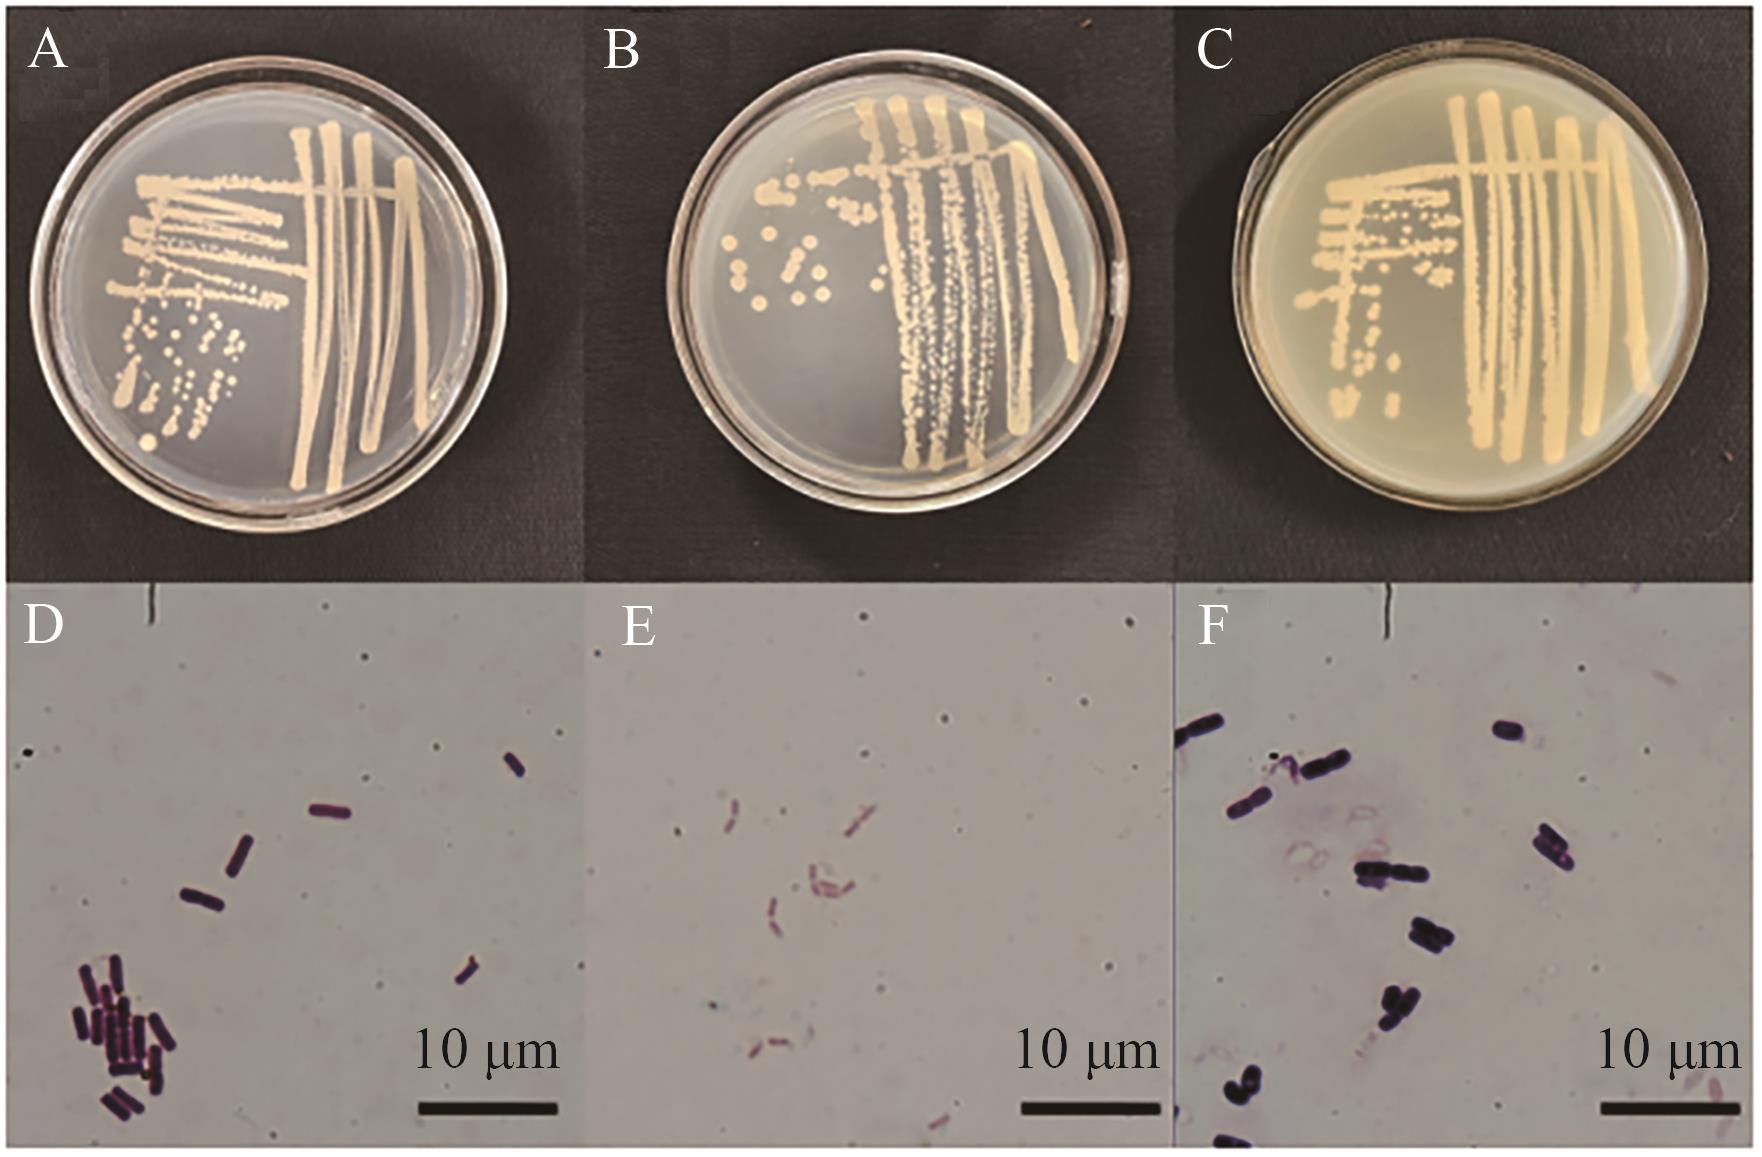

Biotechnology Bulletin ›› 2025, Vol. 41 ›› Issue (4): 302-311.doi: 10.13560/j.cnki.biotech.bull.1985.2024-0978
TONG De-li1( ), ZHANG Xin1, CHEN Jia-qing1, HE Hai-sheng2(
), ZHANG Xin1, CHEN Jia-qing1, HE Hai-sheng2( )
)
Received:2024-10-08
Online:2025-04-26
Published:2025-04-25
Contact:
HE Hai-sheng
E-mail:dltong@synu.edu.cn;hehaisheng@synu.edu.cn
TONG De-li, ZHANG Xin, CHEN Jia-qing, HE Hai-sheng. Isolation of Endophytic Bacteria from Blueberry and Its Alleviative Effects on Brassica chinensis L. under Aluminum Stress[J]. Biotechnology Bulletin, 2025, 41(4): 302-311.

Fig. 1 Bacterial growth at different concentrations of aluminum ions (OD600)Y01, Y02, Y03: Three dominant bacterial strains isolated from blueberry leaf buds. Different letters indicate significant difference (P<0.05). The same below

Fig. 2 Effects of different strains on the growths of Brassica chinensis L. at five aluminium concentrationsAl0‒Al300: Aluminum ion concentration in Brassica chinensis L. hydroponic solution 0‒300 μmol/L

Fig. 5 Effects of strain Y01 on the antioxidant enzyme activities of leaves and roots of B. chinensis L.A‒C: B. chinensis L. leaves. D‒F: B. chinensis L. roots. * indicates P<0.05; ** indicates P<0.01. The same below

Fig. 6 Effects of strain Y01 on the soluble sugars and soluble proteins of leaves and roots of B. chinensis L.A, C: B. chinensis L. leaves. B, D: B. chinensis L. roots
Fig. 7 Morphological observations of the strainA, B, and C are the morphologies of Y01, Y02, and Y03 colonies; D, E, and F are the Gram staining of Y01, Y02, and Y03 under microscope
生理生化反应 Physiological and biochemical reaction | Y01 | Y02 | Y03 |
|---|---|---|---|
| 淀粉水解 Starch hydrolysis | + | + | + |
| 明胶水解 Gelatin hydrolysis | + | + | + |
| 葡萄糖水解 Glucose hydrolysis | + | - | + |
| 接触酶活性 Contactase activity | + | + | + |
| V-P 反应 The V-P reaction | + | - | - |
| 溶血试验 Hemolysis test | + | / | / |
Table 1 Selected physiological and biochemical characteristics of three strains of blueberry endophytic bacteria
生理生化反应 Physiological and biochemical reaction | Y01 | Y02 | Y03 |
|---|---|---|---|
| 淀粉水解 Starch hydrolysis | + | + | + |
| 明胶水解 Gelatin hydrolysis | + | + | + |
| 葡萄糖水解 Glucose hydrolysis | + | - | + |
| 接触酶活性 Contactase activity | + | + | + |
| V-P 反应 The V-P reaction | + | - | - |
| 溶血试验 Hemolysis test | + | / | / |
| 1 | Wang Y, Yao ZS, Zhan Y, et al. Potential benefits of liming to acid soils on climate change mitigation and food security [J]. Glob Chang Biol, 2021, 27(12): 2807-2821. |
| 2 | Xing W, Lu XM, Ying JY, et al. Disentangling the effects of nitrogen availability and soil acidification on microbial taxa and soil carbon dynamics in natural grasslands [J]. Soil Biol Biochem, 2022, 164: 108495. |
| 3 | Zhu QC, Liu XJ, Hao TX, et al. Cropland acidification increases risk of yield losses and food insecurity in China [J]. Environ Pollut, 2020, 256: 113145. |
| 4 | 徐仁扣, 李九玉, 周世伟, 等. 我国农田土壤酸化调控的科学问题与技术措施 [J]. 中国科学院院刊, 2018, 33(2): 160-167. |
| Xu RK, Li JY, Zhou SW, et al. Scientific issues and controlling strategies of soil acidification of croplands in China [J]. Bull Chin Acad Sci, 2018, 33(2): 160-167. | |
| 5 | 张雅茹, 闫磊, 程锦, 等. 硼对铝胁迫下油菜幼苗生长及生理特性的影响 [J]. 中国油料作物学报, 2023, 45(1): 138-147. |
| Zhang YR, Yan L, Cheng J, et al. Effects of boron on growth and physiological characteristics of rape seedlings under aluminum stress [J]. Chin J Oil Crop Sci, 2023, 45(1): 138-147. | |
| 6 | 李颖, 万一兵, 范又维, 等. 铝离子对植物生长发育的影响及耐铝机制研究进展 [J/OL]. 分子植物育种, 2023. . |
| Li Y, Wan YB, Fan YW, et al. Research progress on the effect of Al3+ on plant growth and development and the mechanism of aluminum tolerance [J/OL]. Mol Plant Breed, 2023. . | |
| 7 | 张冉, 韩博, 任健, 等. 铝对植物毒害及草本植物耐铝毒机制研究进展 [J]. 云南农业大学学报: 自然科学, 2020, 35(2): 353-360. |
| Zhang R, Han B, Ren J, et al. Research progress on aluminum toxicity to plants and mechanisms of aluminum tolerance in herbaceous [J]. J Yunnan Agric Univ Nat Sci, 2020, 35(2): 353-360. | |
| 8 | 范伟, 娄和强, 龚育龙, 等. 调控铝诱导根尖有机酸分泌的分子机制 [J]. 植物生理学报, 2014, 50(10): 1469-1478. |
| Fan W, Lou HQ, Gong YL, et al. Molecular mechanisms regulating aluminum-induced secretion of organic acids in root apex [J]. Plant Physiol J, 2014, 50(10): 1469-1478. | |
| 9 | Sasidharan R, Voesenek LA, Pierik R. Cell wall modifying proteins mediate plant acclimatization to biotic and abiotic stresses [J]. Crit Rev Plant Sci, 2011, 30(6): 548-562. |
| 10 | 胡现荣, 范存敏, 吴萍萍, 等. 石灰用量对酸化稻田土壤酸度和水稻产量的影响 [J]. 安徽农业科学, 2023, 51(8): 22-25. |
| Hu XR, Fan CM, Wu PP, et al. Effects of lime dosage on acidification of paddy soil and rice yield [J]. J Anhui Agric Sci, 2023, 51(8): 22-25. | |
| 11 | 闫静, 时仁勇, 王昌军, 等. 不同改良剂对酸性烟田的改良效果及其对烤烟生长的影响 [J]. 土壤, 2023, 55(3): 612-618. |
| Yan J, Shi RY, Wang CJ, et al. Effects of different amendments on soil acidity and tobacco growth in acidic tobacco field [J]. Soils, 2023, 55(3): 612-618. | |
| 12 | 曾廷廷, 蔡泽江, 王小利, 等. 酸性土壤施用石灰提高作物产量的整合分析 [J]. 中国农业科学, 2017, 50(13): 2519-2527. |
| Zeng TT, Cai ZJ, Wang XL, et al. Integrated analysis of liming for increasing crop yield in acidic soils [J]. Sci Agric Sin, 2017, 50(13): 2519-2527. | |
| 13 | 李培培, 仝昊天, 韩燕来, 等. 秸秆直接还田与炭化还田对潮土硝化微生物的影响 [J]. 土壤学报, 2019, 56(6): 1471-1481. |
| Li PP, Tong HT, Han YL, et al. Effect of straw return, directly or as biochar, on nitrifying microbes in fluvo-aquic soil [J]. Acta Pedol Sin, 2019, 56(6): 1471-1481. | |
| 14 | Shahzad A, Siddique A, Ferdous S, et al. Heavy metals mitigation and growth promoting effect of endophytic Agrococcus terreus (MW 979614) in maize plants under zinc and nickel contaminated soil [J]. Front Microbiol, 2023, 14: 1255921. |
| 15 | Jiang XL, Li WW, Han ML, et al. Aluminum-tolerant, growth-promoting endophytic bacteria as contributors in promoting tea plant growth and alleviating aluminum stress [J]. Tree Physiol, 2022, 42(5): 1043-1058. |
| 16 | 裴彤, 周福军, 刘梓强, 等. 外源水杨酸和褪黑素对铝胁迫下蓝莓的缓解作用[J/OL].吉林农业大学学报, 2024. . |
| Pei T, Zhou FJ, Liu ZQ, et al. Study on the alleviative effect of exogenous salicylic acid and melatonin on blueberry under aluminum stress[J/OL]. J Jilin Agric Univ, 2024. . | |
| 17 | 张盈川, 吴晓明玉, 陶保龙, 等. Bna-miR43介导甘蓝型油菜响应干旱胁迫 [J]. 植物学报, 2023, 58(5): 701-711. |
| Zhang YC, Wu XMY, Tao BL, et al. Bna-miR43 mediates the response of drought tolerance in Brassica napus [J]. Chin Bull Bot, 2023, 58(5): 701-711. | |
| 18 | 汤绍虎, 罗充. 植物生理学实验教程 [M]. 重庆: 西南师范大学出版社, 2012. |
| Tang SH, Luo C. Experimental course of plant physiology [M]. Chongqing: Southwest China Normal University Press, 2012. | |
| 19 | 张腾国, 胡馨丹, 李萍, 等. 盐及低温胁迫对油菜ROS和抗氧化酶活性的影响 [J]. 兰州大学学报: 自然科学版, 2019, 55(4): 497-505. |
| Zhang TG, Hu XD, Li P, et al. Effects of low temperature and salt stress on the activity of ROS and antioxidant enzymes in Brassica campestris seedlings [J]. J Lanzhou Univ Nat Sci, 2019, 55(4): 497-505. | |
| 20 | 王晶英, 敖红, 张杰, 等. 植物生理生化实验技术与原理 [M]. 哈尔滨: 东北林业大学出版社, 2003. |
| Wang JY, Ao H, Zhang J, et al. Technology and principle of plant physiology and biochemistry experiment [M]. Harbin: Northeast Forestry University Press, 2003. | |
| 21 | 郜欢欢, 叶桑, 王倩, 等. 甘蓝型油菜种子萌发期耐铝毒特性综合评价及其种质筛选 [J]. 作物学报, 2019, 45(9): 1416-1430. |
| Gao HH, Ye S, Wang Q, et al. Screening and comprehensive evaluation of aluminum-toxicity tolerance during seed germination in Brassca napus [J]. Acta Agron Sin, 2019, 45(9): 1416-1430. | |
| 22 | 韩德鹏, 刘星月, 王馨悦, 等. 铝胁迫对油菜根系形态和生理指标的影响 [J]. 核农学报, 2019, 33(9): 1824-1832. |
| Han DP, Liu XY, Wang XY, et al. Effects of aluminum stress on morphology parameters of roots and physiological indexes in Brassica napus L [J]. J Nucl Agric Sci, 2019, 33(9): 1824-1832. | |
| 23 | 邓晓霞, 李月明, 姚堃姝, 等. 植物适应酸铝胁迫机理的研究进展 [J]. 生物工程学报, 2022, 38(8): 2754-2766. |
| Deng XX, Li YM, Yao KS, et al. Advances in the mechanism of plant adaptation to acid aluminum stress [J]. Chin J Biotechnol, 2022, 38(8): 2754-2766. | |
| 24 | 陈泰林, 钱春梅, 张建军, 等. 植物铝胁迫响应机制的研究进展 [J]. 热带农业科学, 2010, 30(2): 37-48, 86. |
| Chen TL, Qian CM, Zhang JJ, et al. Advances of mechanism of plant response to aluminum stress [J]. Chin J Trop Agric, 2010, 30(2): 37-48, 86. | |
| 25 | 于天一, 孙秀山, 石程仁, 等. 土壤酸化危害及防治技术研究进展 [J]. 生态学杂志, 2014, 33(11): 3137-3143. |
| Yu TY, Sun XS, Shi CR, et al. Advances in soil acidification hazards and control techniques [J]. Chin J Ecol, 2014, 33(11): 3137-3143. | |
| 26 | 吴林坤, 林向民, 林文雄. 根系分泌物介导下植物-土壤-微生物互作关系研究进展与展望 [J]. 植物生态学报, 2014, 38(3): 298-310. |
| Wu LK, Lin XM, Lin WX. Advances and perspective in research on plant-soil-microbe interactions mediated by root exudates [J]. Chin J Plant Ecol, 2014, 38(3): 298-310. | |
| 27 | Ali H, Khan E. What are heavy metals? Long-standing controversy over the scientific use of the term 'heavy metals'-proposal of a comprehensive definition [J]. Toxicol Environ Chem, 2018, 100(1): 6-19. |
| 28 | 赵会娥, 贺立源, 章爱群, 等. 铝胁迫对植物光合作用的影响及其机理的研究进展 [J]. 华中农业大学学报, 2008, 27(1): 155-160. |
| Zhao HE, He LY, Zhang AQ, et al. Advance in the study of effects of aluminum stress on plant photosynthesis and its mechanism [J]. J Huazhong Agric Univ, 2008, 27(1): 155-160. | |
| 29 | Zhang J, He L, Guo C, et al. Evaluation of Aspergillus aculeatus GC-09 for the biological control of citrus blue mold caused by Penicillium italicum [J]. Fungal Biol, 2022, 126(3): 201-212. |
| 30 | 符京燕, 梁林林, 周敏, 等. 伽马氨基丁酸浸种对铝胁迫下白三叶种子萌发及耐铝性的影响 [J]. 草地学报, 2020, 28(5): 1275-1284. |
| Fu JY, Liang LL, Zhou M, et al. Effects of seeds soaking with γ-aminobutyric acid on germination and aluminium tolerance of white clover [J]. Acta Agrestia Sin, 2020, 28(5): 1275-1284. | |
| 31 | 田茂燕, 向婷颖, 钟川, 等. 番茄砧木耐热性评价及热胁迫生理响应研究 [J]. 中国蔬菜, 2021(5): 39-47. |
| Tian MY, Xiang TY, Zhong C, et al. Evaluation of tomato rootstock heat resistance and studies on its physiological response to heat stress [J]. China Veg, 2021(5): 39-47. | |
| 32 | 张雯, 黄益丹, 张鹏超, 等. 甘蓝型油菜耐铝极端品种筛选及耐铝生理机制初步解析 [J]. 华中农业大学学报, 2023, 42(6): 154-163. |
| Zhang W, Huang YD, Zhang PC, et al. Screening extreme varieties with aluminum tolerance and analyzing physiological mechanisms of aluminum tolerance in Brassica napus [J]. J Huazhong Agric Univ, 2023, 42(6): 154-163. | |
| 33 | 刘强, 胡华良, 苏柳, 等. 不同有机物料对铝毒土壤上油菜生长的缓解效应研究 [J]. 井冈山大学学报: 自然科学版, 2010, 31(2): 22-25. |
| Liu Q, Hu HL, Su L, et al. Alleviation effect of different organic manures on rape seedings grown in aluminum toxicity soil [J]. J Jinggangshan Univ Nat Sci, 2010, 31(2): 22-25. | |
| 34 | 刘燕, 罗文敏, 段如雁, 等. 威宁地区茶树种质资源的抗旱性研究 [J]. 西南农业学报, 2022, 35(3): 530-535. |
| Liu Y, Luo WM, Duan RY, et al. Study on drought-resistant tea cultivars in Weining county [J]. Southwest China J Agric Sci, 2022, 35(3): 530-535. | |
| 35 | Plett JM, Plett KL, Wong-Bajracharya J, et al. Mycorrhizal effector PaMiSSP10b alters polyamine biosynthesis in Eucalyptus root cells and promotes root colonization [J]. New Phytol, 2020, 228(2): 712-727. |
| 36 | 赵龙飞, 徐亚军, 邵璇, 等. 两株内生芽孢杆菌对盐胁迫下大豆幼苗超氧化物歧化酶和过氧化物酶活性影响 [J]. 微生物学通报, 2022, 49(5): 1664-1677. |
| Zhao LF, Xu YJ, Shao X, et al. Two endophytic Bacillus strains from soybean nodules affect superoxide dismutase and peroxidase activities in soybean seedlings under salt stress [J]. Microbiol China, 2022, 49(5): 1664-1677. |
| [1] | LI Qing-mao, PENG Cong-gui, QI Xiao-han, LIU Xing-lei, LI Zhen-yuan, LI Qin-yan, HUANG Li-yu. Screening and Identification of Excellent Strains of Endophytic Bacteria Promoting Rice Iron Absorption from Wild Rice [J]. Biotechnology Bulletin, 2024, 40(8): 255-263. |
| [2] | KONG De-ting, QI Xiao-han, LIU Xing-lei, LI Li-ping, HU Feng-yi, HUANG Li-yu, QIN Shi-wen. Comparison and Analysis of Endophytic Bacterial Communities in Different Perennial Rice Varieties [J]. Biotechnology Bulletin, 2024, 40(5): 225-236. |
| [3] | WANG Yu, YIN Ming-shen, YIN Xiao-yan, XI Jia-qin, YANG Jian-wei, NIU Qiu-hong. Screening, Identification and Degradation Characteristics of Nicotine-degrading Bacteria in Lasioderma serricorne [J]. Biotechnology Bulletin, 2023, 39(6): 308-315. |
| [4] | LI Yi-jun, WU Chen-chen, LI Rui, WANG Zhe, HE Shan-wen, WEI Shan-jun, ZHANG Xiao-xia. Exploring Cultivation Approaches for New Endophytic Bacterial Resource in Oryza sativa [J]. Biotechnology Bulletin, 2023, 39(4): 201-211. |
| [5] | LUO Yan-ju, XIE Lin-yan, ZOU Qing-lin, LI Si-jie, LIU Han, LIU Lu-feng, HE Li-lian, LI Fu-sheng. Physiological Response and Drought Resistance Evaluation of Endophytic Bacteria to Sugarcane Under Drought Stress [J]. Biotechnology Bulletin, 2023, 39(12): 219-228. |
| [6] | ZOU Lan, WANG Qian, LI Mu-yi, YE Kun-hao, HUANG Jing. Identification, Biocontrol and Plant Growth-promoting Potential of Endophytic Bacterial Strain JY-3-1R from Aconitum carmichaelii Debx. [J]. Biotechnology Bulletin, 2023, 39(10): 246-255. |
| [7] | HE Li-na, FENG Yuan, SHI Hui-min, YE Jian-ren. Screening and Identification of Endophytic Bacteria with Nematicidal Activity Against Bursaphelenchus xylophilus in Pinus massoniana [J]. Biotechnology Bulletin, 2022, 38(8): 159-166. |
| [8] | GAO Xiao-ning, LIU Rui, WU Zi-lin, WU Jia-yun. Characteristics of Endophytic Fungal and Bacterial Community in the Stalks of Sugarcane Cultivars Resistant to Ratoon Stunting Disease [J]. Biotechnology Bulletin, 2022, 38(6): 166-173. |
| [9] | WANG Chun-yan, LA Gui-xiao, SU Xiu-hong, LI Meng, DONG Cheng-ming. Screening of Endophytic Bacteria from Rehmannia glutinosa at Different Stages and Analysis of Their Growth-promoting Characteristics [J]. Biotechnology Bulletin, 2022, 38(4): 242-252. |
| [10] | WANG Zhi-shan, LI Ni, WANG Wei-ping, LIU Yang. Research Progress in Endophytic Bacteria in Rice Seeds [J]. Biotechnology Bulletin, 2022, 38(1): 236-246. |
| [11] | TANG Jia-cheng, LIANG Yi-min, MA Jia-si, PENG Gui-xiang, TAN Zhi-yuan. Diversity and Growth Promotion of Endophytic Bacteria Isolated from Passiflora edulia Sims [J]. Biotechnology Bulletin, 2022, 38(1): 86-97. |
| [12] | ZHU Hai-yun, MA Yu, KE Yang, LI Bo. Screening and Identification of an Antagonist Against the Pathogen of Kiwifruit Canker and Its Antifungal Activity to the Phytopathogenic Fungus [J]. Biotechnology Bulletin, 2021, 37(6): 66-72. |
| [13] | GUO Xiao-ping, LIU Xing-fei, LI Xiao-nan, LÜ Xue-ru, XI Shao-mei, TIAN Yuan. Study on Antifungal Activity of an Endophytic Bacterium of Polygonatum sibiricum Delar. ex Redoute [J]. Biotechnology Bulletin, 2020, 36(11): 48-54. |
| [14] | LIU Jun-sheng, XIE Xiu-chao, LUO Yang-lan, DENG Bai-wan, BAI Qiu-yue, YAN Meng-chen, BAI Xing. Isolation,Identification,and Biological Characteristics of a Cadmium-Resistant Endophytic Bacteria Bacillus aryabhattai [J]. Biotechnology Bulletin, 2019, 35(2): 64-72. |
| [15] | LIN Li, LI Yang-rui, AN Qian-li. Biological Nitrogen Fixation in Association with Sugarcane:Retrospect and Prospect [J]. Biotechnology Bulletin, 2019, 35(10): 46-56. |
| Viewed | ||||||
|
Full text |
|
|||||
|
Abstract |
|
|||||